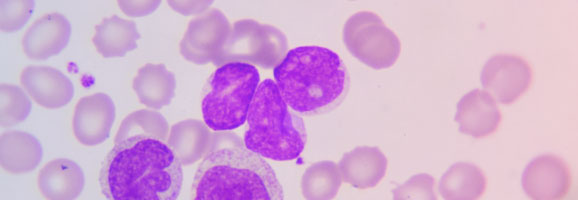
Histologische Aufnahme „Leukämiezellen“ zeigt mikroskopische Aufnahme von abnormen weißen Blutkörperchen.

Produkte von Incyte – Übersicht für Fachkreise
UNSERE ZUGELASSENEN THERAPIEMÖGLICHKEITEN JE NACH INDIKATION
Incyte bietet 4 Therapien für 5 verschiedene Indikationen an. Für Angehörige medizinischer Fachkreise haben wir alle relevanten, aktuellen Informationenen und Download-Materialien rund um unsere Produkte zusammengestellt. Klicken Sie auf eine der Kacheln, um mehr zu erfahren.